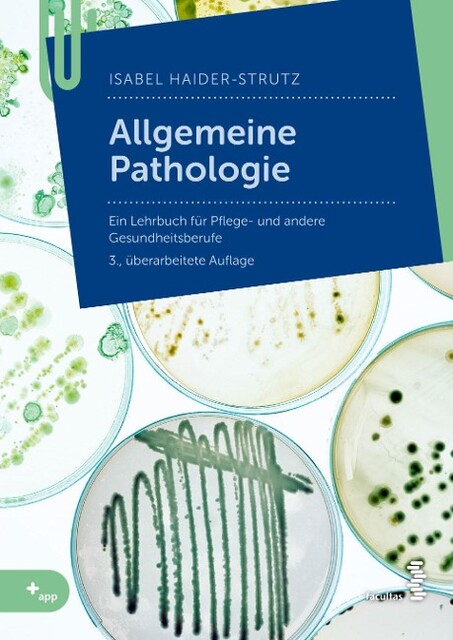

Allgemeine Pathologie
für Pflege- und andere Gesundheitsberufe
- Verlag: facultas.wuv Universitäts
- Umfang: 230 Seiten
- Auflage: 3. Auflage
- Erscheinungsjahr: 2022
- Bestellnummer: 37849
- ISBN: 9783708921709
-
fehlt kurzfristig am Lager
I care – Einfach leichter lernen Mit der Nummer 1 für die Pflegeausbildung Du willst in deiner Pflegeausbildung durchstarten und sicher durch die Prüfungen kommen? Mit I care hast du alles, was du brauchst –
...alles anzeigendetailliert in deinem Lehrbuch und kompakt in der kostenlosen Lern-App. Warum I care Pflege? - Alles drin: Die gesamte Pflege für alle Settings mit allen Pflegetechniken - vernetzt und kompakt für dich aufbereitet. Inklusive Grundlagen der Krankheitslehre und Anatomie - Lernen leicht gemacht: Mindmaps, Infografiken und WISSEN TO GO-Boxen zum Schnelllernen geben dir den perfekten Überblick zu den pflegerischen Themen. - Sicherheit im Alltag: Schritt-für-Schritt-Anleitungen, Pflegediagnosen und Fallbeispiele bereiten dich optimal vor. - Immer dabei: Dein Buch gibt’s auch digital. Einfach Code eingeben auf icare.thieme.de. - Kostenlose Lern-App: Digitale Lernkarten mit deinem persönlichen Lernerfolg sowie Videos zu Pflegehandlungen hast du in der I care WISSEN TO GO App. Auf deine Ausbildung zugeschnitten! - alles nach Plan – erfüllt die Inhalte nach PflAPrV und gemäß PflBG - aus deiner Sicht geschrieben – verständlich und praxisnah formuliert - schnell und effektiv lernen – mit Zusammenfassungen für einfaches Wiederholen und Anwenden Neu im angesagten Farbschnitt – so hast du Lehrbücher noch nie gesehen. Die Themen in I care Pflege: - Grundlagen des Pflegeberufs - Mit Menschen arbeiten - Pflegebasismaßnahmen - Pflegetechniken - Menschen in unterschiedlichen Settings pflegen - Pflege von Menschen mit speziellen Erkrankungen Neu in der 3. Auflage: - Konkrete Hinweise zum Arbeiten mit Pflegediagnosen im praktischen Pflegealltag, orientiert an speziellen gesundheitlichen Problemlagen. - Themenfelder wie Lebensgestaltung, pädiatrische Pflege oder präventive Pflege in der ambulanten Pflege wurden deutlich erweitert. Tipp: Kombiniere I care Pflege mit I care Krankheitslehre und I care Anatomie, Physiologie für dein Komplett-Paket! Die Bücher sin
Das seit dem 1.1.2020 geltende Pflegeberufegesetz führt die Alten-, Kranken- und Kinderkrankenpflegeausbildungen unter der einheitlichen Berufsbezeichnung „Pflegefachfrau/-mann“ zusammen. Damit wird die Ausbild
...alles anzeigenung samt ihrer Finanzierung auf eine einheitliche Rechtsgrundlage gestellt und auch an Hochschulen als Regelausbildung ermöglicht.In diesem Kommentar werden die Rechtsgrundlagen der Berufsausbildung und -zulassung einschließlich der Ausbildungs- und Prüfungsverordnung ausführlich dargestellt und praxisorientiert erläutert.Für die 3. Auflage wurden alle Gesetzesänderungen berücksichtigt, u.a. die hochschulische Pflegeausbildung mit dem Pflegestudiumstärkungsgesetz und die Erweiterung um Kompetenzen zur Ausübung heilkundlicher Aufgaben.„Eine wissenschaftlich fundierte und dabei gleichzeitig äußerst praxisorientierte Erläuterung, die insbesondere für Ausbildungsträger, Schulen und Aufsichts- bzw. Prüfbehörden ein unverzichtbares Nachschlagewerk darstellt. Für diesen Adressatenkreis ist das Buch ein absolutes Muss!“ (Prof. Dr. Peter Kostorz, socialnet).Unter Mitarbeit von Annette Malottke.InhaltsverzeichnisDie dritte vollständig aktualisierten Auflage des Kommentars zum Pflegeberufegesetz und zur Pflegeberufe- Ausbildungs- und -Prüfungsverordnung berücksichtigt die aktuelle Rechtsprechung sowie die zahlreichen Neuregelungen seit dem ersten Inkrafttreten im Jahr 2020. Mit dem Pflegestudiumstärkungsgesetz (2023) wurde insbesondere die hochschulische Pflegeausbildung als duales Studium arbeitsrechtlich neu gestaltet und das Prüfungsverfahren an die hierzu erfolgte Rechtsprechung angepasst. Die Ausbildungsziele werden in der Hochschulausbildung ab 2025 um heilkundliche Tätigkeiten erweitert. Vorgaben der EU-Berufsanerkennungsrichtlinie zur partiellen Berufsausübung wurden in deutsches Recht umgesetzt. Ein unverzichtbares Nachschlagewerk für alle, die mit der Pflegeausbildung befasst sind.
Nach der Erststudie „Coolout in der Pflege“ (ISBN: 978-3-940529-99-2) präsentiert dieser Band neue Studien zur beruflichen Situation der PflegepädagogInnen und PraxisanleiterInnen. Diese finden sich ebenso wie
...alles anzeigenPflegekräfte und Auszubildende in der Pflege mit dem unauflösbaren Widerspruch zwischen Patientenorientierung und ökonomischen Zwängen konfrontiert.Mit der Metapher der „Bürgerlichen Kälte“ wird erklärt, wie sie diesen Widerspruch in ihrem Arbeitsalltag einerseits aushalten können und andererseits damit zur Stabilisierung einer erklärtermaßen normativ inakzeptablen Praxis beitragen: Sie lernen, sich kalt zu machen.Die Ergebnisse der neuen Studien werden im Zusammenhang mit ausgewählten Anleitungs- bzw. didaktischen Konzepten diskutiert. Aus den Schlussfolgerungen leitet die Autorin Vorschläge für eine kritische Pflegedidaktik ab.
Pflege bewegt sich an Grenzen, bei deren Überschreitung die Würde leicht verletzt wird: Grenzen der Nacktheit, der Privatheit, der Intimität. Wird unsere Würde oder die eines anderen Menschen verletzt, empfinde
...alles anzeigenn wir Scham. Wenn Gefühle der Scham bewusst wahrgenommen und gedeutet werden, kann diese ihre schützende Funktion als "Wächterin menschlicher Würde" entfalten.Dieser Ratgeber hilft, Würde und Scham in Pflegesituationen besser zu verstehen. Anschauliche Beispiele zeigen, hinter welchen Masken Scham sich verbergen kann und welche Rahmenbedingungen den angemessenen Umgang mit Schamgrenzen erschweren. Die Perspektive der Pflegenden (Laien und Professionelle) wird ebenso berücksichtigt wie die Perspektive der Menschen, denen Pflege zuteilwird.Eine einzigartige Unterstützung für alle, die Pflege menschenwürdig gestalten wollen!